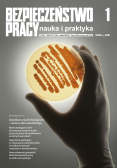

| 1/2018 |
|
- Szkodliwe czynniki biologiczne – ocena ryzyka zawodowego
- Nowe wymagania norm do oceny parametrów drabin
- Zagrożenia wynikające ze stosowania nanomateriałów w środkach smarnych
- Uwarunkowania gotowości do kontynuowania pracy w wieku emerytalnym
|
|
| 2/2018 |
 |
- Stres w pracy personelu medycznego psychiatrycznej opieki zdrowotnej – przegląd badań
- Modelowanie systemów zarządzania bhp z wykorzystaniem metody rozmytych map kognitywnych i wskaźników wiodących
- Zagrożenia dla zdrowia w pracy sprzedawcy w handlu detalicznym
- Analiza zagrożeń uszkodzeń głowy pracownika podczas powstrzymywania spadania z wysokości
|
|
| 3/2018 |
 |
- Antycypowanie szans i zagrożeń w rezylientnym systemie zarządzania bezpieczeństwem i higieną pracy
- System aktywnej redukcji hałasu do zastosowania w hełmach strażackich – propozycja rozwiązania
- Uznawanie kwalifikacji nabytych w Unii Europejskiej do wykonywania w Polsce zawodów regulowanych w dziedzinie bhp
- Samoocena zdrowia oraz dbałości o nie aktywnych zawodowo mężczyzn – wstępne wyniki badań
|
|
| 4/2018 |
 |
- Szkodliwe czynniki biologiczne w środowisku pracy zakładów przemysłu mleczarskiego
- Ocena właściwości ochronnych wkładek antyprzebiciowych w obuwiu
- Zaangażowanie w pracę jako czynnik zmniejszający ryzyko stresu zawodowego
- Inteligentne systemy transportowe a bezpieczeństwo uczestników ruchu drogowego
|
|
| 5/2018 |
 |
- Sposoby utrzymywania sprawności fizycznej przez strażaków – wyniki badań własnych
- Ubranie specjalne dla strażaków – wymagania normatywne i badania własne
- Uczenie się pracowników starszych – raport wstępny z badań
- Praca mobilna oparta na technologiach informacyjno-komunikacyjnych
|
|
| 6/2018 |
 |
- Narażenie na hałas podczas meczu piłkarskiego
- Problemy związane z rozpoznawaniem barw świateł sygnalizacyjnych
- Parametry użytkowe filtrów powietrza w ogólnej wentylacji i klimatyzacji
- Wymagania prawne dotyczące akcesoriów odblaskowych stosowanych przez pieszych
|
|
| 7/2018 |
 |
- Pojęcie wypadku przy pracy rolniczej
- Motywy podejmowania kształcenia na studiach podyplomowych z zakresu bhp oraz doświadczenia edukacyjne absolwentów
- Analiza przyczyn i konsekwencji wypadków przy pracy ratowników Państwowej Straży Pożarnej w latach 2010 – 2016
- Źródła informacji w zakresie bezpieczeństwa pracy w bibliotekach – na przykładzie zasobów biblioteki CIOP-PIB
|
|
| 8/2018 |
 |
- Kaski sportowo-rekreacyjne – konstrukcja i wymagania norm
- Wymagania funkcjonalne wobec inteligentnej odzieży dla ratowników górskich
- Mózg po godzinach: wpływ pracy zmianowej na funkcjonowanie poznawcze pracowników
- Stacjonarne urządzenia komputerowe – rozpoznanie i ocena pola elektromagnetycznego w przestrzeni pracy
|
|
| 9/2018 |
 |
- Półmaski filtrujące do ochrony przed smogiem
- Preferencje strażaków w odniesieniu do odzieży spodniej i
- Lęk i stres – jak radzą sobie z nimi policjanci? Wyniki badań własnych
- Ergonomia pracy a schorzenia narządu ruchu wśród lekarzy stomatologów
|
|
| 10/2018 |
 |
- Sytuacja osób niepełnosprawnych na polskim rynku pracy i jej determinanty
- Zarządzanie pozycjonowaniem osób niepełnosprawnych słuchowo w organizacji
- Formy zatrudnienia a postawy wobec pracy na przykładzie badanych przedsiębiorstw budowlanych
- Ocena wymagań jako wyzwań i przeszkód w pracy i jej wpływ na efektywność i dobrostan pracowników
- Nierówności na rynku pracy na przykładzie sektorów BPO i SSC w Polsce
- Stanowisko badawcze CIOP-PIB do badań percepcji dźwięku przestrzennego z zastosowaniem techniki ambisonicznej
|
|
| 11/2018 |
 |
- Ocena wiedzy pielęgniarek bloku operacyjnego w zakresie ochrony radiologicznej
- Rola pielęgniarki służby medycyny pracy
- Ocena położenia przedramion i nadgarstków w trakcie wykonywania czynności zawodowych przez higienistkę stomatologiczną
- Pracujący, ale biedni. Wybrane aspekty zjawiska "biednych pracujących" w Europie – analiza taksonomiczna
|
|
| 12/2018 |
 |
- Warunki pracy w Polsce i Europie – przegląd wyników badań europejskich
- Perspektywa cyklu życia i starzenie się pracowników w aspekcie polityki publicznej
- Warunki pracy w wybranych pomieszczeniach szpitala
- Upadki z wysokości na placu budowy wynikające z nieprawidłowego stosowania środków ochrony zbiorowej
|
|




